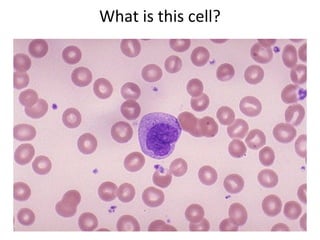
What is this cell?
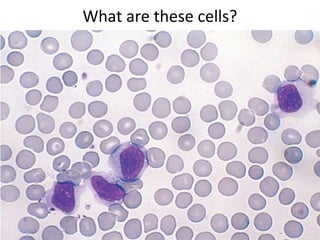
What are these cells?
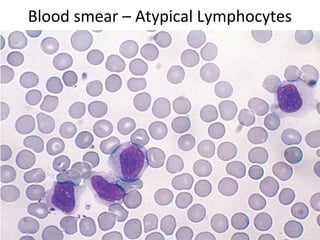
Blood smear – Atypical Lymphocytes
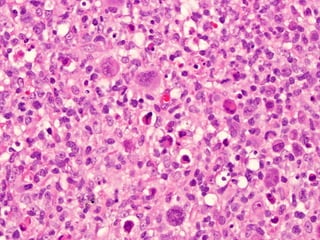

Infectious mononucleosis is caused by the Epstein-Barr virus. It presents with fever, sore throat, lymphadenopathy, and sometimes hepatitis, meningitis or pneumonia. The virus infects B cells in the throat and establishes latent infection. Diagnosis involves finding atypical lymphocytes in blood and a positive monospot test. Complications can include splenic rupture, chronic fatigue, or lymphoma in rare cases.